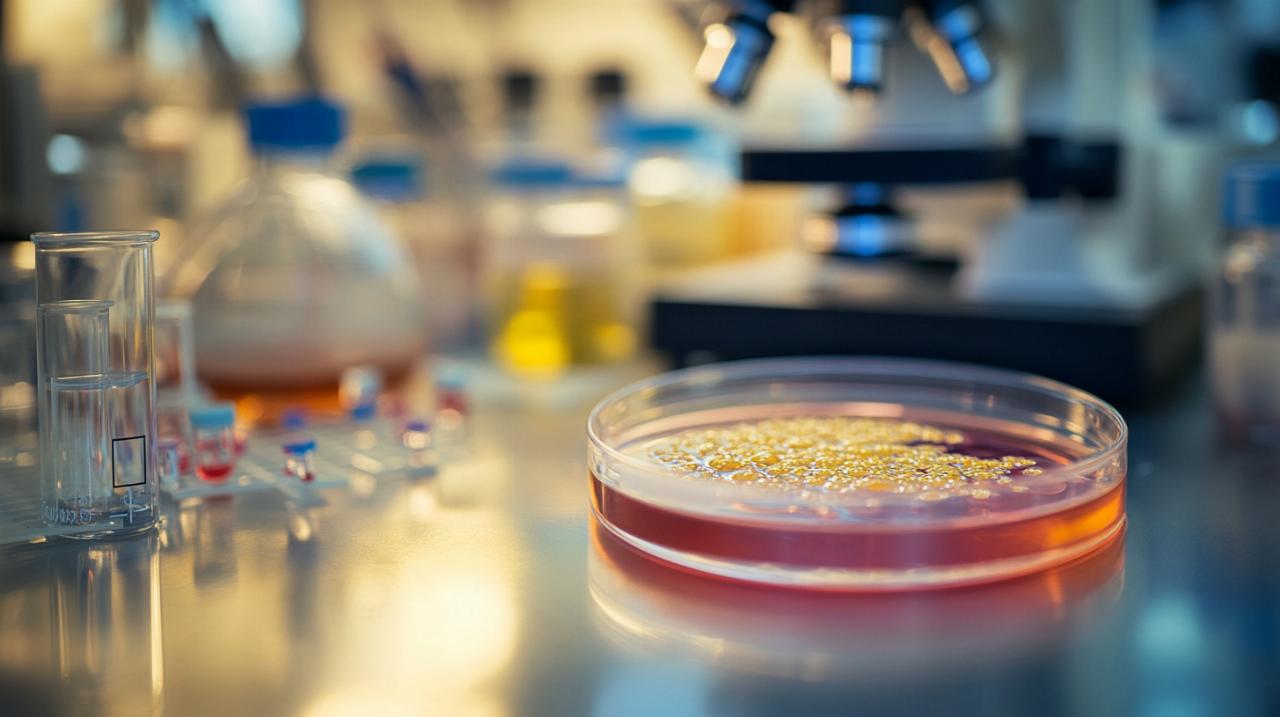

Les boîtes de Petri constituent un équipement incontournable dans tout laboratoire, qu'il soit professionnel, éducatif ou amateur. Ces récipients cylindriques peu profonds permettent la culture et l'observation de micro-organismes, de cellules ou même de petits végétaux sur un milieu gélifié. Accessibles financièrement et disponibles en différentes configurations, elles offrent une solution pratique pour mener des expérimentations scientifiques rigoureuses. Leur utilisation s'étend de la recherche fondamentale aux applications mycologiques, en passant par l'enseignement et les tests microbiologiques.
Comprendre les différents types de boîtes de Petri disponibles sur le marché
Le marché propose une gamme variée de boîtes de Petri adaptées à différents besoins et contraintes budgétaires. Cette diversité permet aux utilisateurs de sélectionner le matériel le plus approprié selon leurs exigences spécifiques et la nature de leurs cultures.
Boîtes en verre versus boîtes en plastique : avantages et applications
Les boîtes de Petri en verre, fabriquées en Pyrex ou en Duran, représentent l'option traditionnelle privilégiée pour leur durabilité et leur capacité à être réutilisées après stérilisation. Ces récipients résistent parfaitement aux températures élevées nécessaires à l'autoclavage et conservent leurs propriétés optiques au fil des utilisations. Ils conviennent particulièrement aux laboratoires disposant d'équipements de stérilisation et cherchant une solution économique sur le long terme.
Les boîtes en plastique, généralement fabriquées en polystyrène, offrent quant à elles des avantages distincts. Proposées en lots, souvent stériles pour un usage unique, elles éliminent la nécessité de stérilisation entre chaque utilisation. Cette caractéristique garantit un niveau de stérilité optimal et réduit considérablement les risques de contamination croisée. Leur légèreté facilite également la manipulation et le stockage en grande quantité. Les boîtes en plastique sont idéales pour les applications nécessitant une stérilité absolue et pour les structures ne disposant pas d'équipements de stérilisation sophistiqués.
Les caractéristiques techniques : dimensions, stérilité et systèmes de ventilation
Les dimensions constituent un critère essentiel dans le choix d'une boîte de Petri. Les modèles standards mesurent généralement 94x16mm, une taille polyvalente adaptée à la plupart des applications courantes. Certains fournisseurs proposent néanmoins des dimensions variées pour répondre à des besoins spécifiques, permettant d'adapter le volume de milieu de culture et la surface d'observation disponible.
La stérilité représente un paramètre fondamental pour garantir la qualité des cultures. Les boîtes stériles préemballées assurent un environnement exempt de contaminants dès l'ouverture, condition indispensable pour des résultats fiables. Certains modèles intègrent des systèmes de ventilation conçus pour optimiser les échanges gazeux nécessaires à la croissance des cultures. Ces dispositifs permettent l'apport d'oxygène et l'évacuation du dioxyde de carbone tout en maintenant une barrière contre les contaminants aéroportés.
Les boîtes à compartiments offrent la possibilité de réaliser plusieurs cultures distinctes simultanément dans un même récipient, facilitant les études comparatives. Les modèles rotatifs permettent quant à eux une distribution homogène du milieu lors du coulage. Enfin, la présence d'ergots facilite grandement la manipulation en permettant une prise en main aisée et en empêchant le glissement du couvercle, aspect particulièrement apprécié lors des observations sous microscope ou dans les hottes à flux laminaire.
Préparer efficacement vos milieux de culture agar et bouillon
La préparation des milieux de culture constitue une étape déterminante pour la réussite des expérimentations. La qualité du milieu influencera directement la croissance des organismes cultivés et la fiabilité des résultats obtenus.
Les étapes de préparation du milieu agar pour vos cultures
La préparation d'un milieu agar débute par la sélection d'une formulation adaptée aux organismes ciblés. Les milieux nutritifs se composent généralement d'extraits de levure, de peptones, de sels minéraux et d'agar comme agent gélifiant. La précision dans les proportions garantit la reproductibilité des conditions de culture.
Le processus commence par la pesée rigoureuse des différents composants selon la formulation choisie. Ces ingrédients sont ensuite dissous dans de l'eau distillée ou déminéralisée, avec un chauffage progressif sous agitation constante. Un mélangeur magnétique s'avère particulièrement utile pour assurer une dissolution homogène des composants et éviter la formation de grumeaux. La température doit être élevée progressivement jusqu'à ébullition pour permettre la dissolution complète de l'agar et assurer la stérilité du milieu.
Une fois le milieu préparé, il convient de procéder à son ajustement de pH si nécessaire, puis à sa stérilisation par autoclavage à 121 degrés Celsius pendant quinze à vingt minutes. Cette étape élimine tout micro-organisme pouvant contaminer les cultures ultérieures. Après stérilisation, le milieu doit être refroidi jusqu'à environ cinquante degrés Celsius avant d'être coulé dans les boîtes de Petri pour éviter la formation de condensation excessive sur les couvercles.
Techniques de coulage et de conservation des milieux dans les boîtes de Petri
Le coulage du milieu agar représente une opération délicate qui doit être réalisée dans des conditions d'asepsie rigoureuses, idéalement sous une hotte à flux laminaire ou à proximité d'un bec Bunsen créant un flux d'air ascendant protecteur. Le port de gants en nitrile et d'un masque de protection à trois couches constitue une précaution indispensable pour éviter toute contamination par l'opérateur.
La quantité de milieu coulée doit être suffisante pour recouvrir le fond de la boîte sur environ trois à cinq millimètres d'épaisseur, assurant ainsi une surface de culture adéquate sans gaspillage de matériel. Le coulage s'effectue en soulevant légèrement le couvercle de la boîte, en versant le milieu rapidement mais sans créer de bulles, puis en refermant immédiatement pour limiter l'exposition à l'air ambiant. Les boîtes doivent ensuite être laissées au repos sur une surface plane jusqu'à solidification complète du gel, processus qui prend généralement entre quinze et trente minutes.
La conservation des boîtes préparées s'effectue idéalement à l'envers, couvercle en bas, pour éviter que la condensation ne tombe sur la surface du milieu et ne favorise la croissance de contaminants. Stockées au réfrigérateur entre deux et huit degrés Celsius, ces boîtes peuvent être conservées plusieurs semaines dans des sacs plastiques hermétiques pour prévenir la dessiccation du milieu. Avant utilisation, il convient de les ramener à température ambiante pour éviter les chocs thermiques qui pourraient perturber les cultures.
Choisir la boîte de Petri adaptée à vos besoins de laboratoire
La sélection d'une boîte de Petri appropriée repose sur une analyse précise des exigences expérimentales et des caractéristiques des organismes à cultiver. Cette démarche garantit l'obtention de résultats fiables et reproductibles.
Critères de sélection selon le type de culture et d'organisme
Pour la culture de champignons et la production de cultures mères, les boîtes stériles avec agar préparées constituent une solution particulièrement pratique. Ces boîtes, proposées par des fournisseurs spécialisés comme Mycelinarium pour environ dix euros quatre-vingt-quinze le lot de cinq pièces, permettent de démarrer immédiatement les cultures sans nécessiter de préparation préalable. Elles conviennent parfaitement à la multiplication et à l'analyse du mycélium, phases essentielles dans la culture mycologique.
Les cultures bactériennes nécessitent généralement des boîtes offrant une excellente transparence pour faciliter l'observation des colonies et des caractéristiques morphologiques. Les modèles en polystyrène transparent répondent admirablement à cette exigence tout en garantissant un environnement stérile. Pour les cultures nécessitant des conditions anaérobies ou microaérophiles, les boîtes équipées de systèmes de ventilation contrôlée permettent de moduler les échanges gazeux selon les besoins spécifiques des organismes cultivés.
Les applications nécessitant des tests comparatifs bénéficient grandement des boîtes à compartiments, qui permettent d'évaluer simultanément plusieurs conditions expérimentales dans un environnement contrôlé identique. Cette configuration réduit la variabilité expérimentale et facilite l'interprétation des résultats. Pour des commandes importantes ou des besoins très spécifiques, certains fournisseurs proposent d'établir un devis personnalisé, permettant d'obtenir exactement le matériel requis dans les quantités nécessaires.
Accessoires complémentaires : portoirs, supports et rangements
L'organisation efficace du matériel de laboratoire contribue significativement à l'amélioration de la productivité et à la réduction des risques de contamination. Les portoirs en acier inoxydable représentent un investissement judicieux pour faciliter le rangement et le transport des boîtes de Petri. Ces supports robustes permettent d'empiler plusieurs boîtes de manière stable, optimisant ainsi l'utilisation de l'espace dans les incubateurs et les réfrigérateurs.
Pour les laboratoires traitant un volume important d'échantillons, des systèmes de rangement modulaires permettent une organisation rationnelle par projet, date ou type de culture. Cette approche structurée facilite la traçabilité des expérimentations et réduit le temps consacré à la recherche de cultures spécifiques. Certains dispositifs pour décanter complètent l'équipement en permettant la séparation de phases liquides lors de la préparation de certains milieux complexes.
Les ampoules et béchers constituent également du matériel complémentaire utile pour la préparation des solutions mères et la dilution des milieux concentrés. Leur association avec les boîtes de Petri permet de couvrir l'ensemble des besoins en matériel de base pour un laboratoire fonctionnel. De nombreux fournisseurs proposent la livraison gratuite à partir d'un certain montant d'achat, rendant l'acquisition de ce matériel encore plus économique lors de commandes groupées.
Optimiser l'utilisation et l'entretien de vos boîtes de Petri
L'exploitation optimale des boîtes de Petri implique le respect de protocoles rigoureux tant au niveau de la stérilisation que de la manipulation des cultures. Ces bonnes pratiques garantissent la fiabilité des résultats et la sécurité des opérateurs.
Protocoles de stérilisation pour les boîtes réutilisables
Les boîtes de Petri en verre nécessitent une stérilisation minutieuse entre chaque utilisation pour éliminer tout résidu organique et micro-organisme. Le processus débute par un nettoyage mécanique approfondi utilisant un détergent adapté au matériel de laboratoire. Les boîtes doivent être frottées soigneusement pour éliminer les résidus de milieu gélifié, puis rincées abondamment à l'eau courante pour éliminer toute trace de détergent.
Un rinçage final à l'eau distillée ou déminéralisée prévient les dépôts minéraux qui pourraient interférer avec les observations microscopiques ultérieures. Les boîtes sont ensuite séchées complètement, soit à l'air libre dans un environnement protégé, soit dans une étuve ventilée à température modérée. L'humidité résiduelle favoriserait la prolifération microbienne et compromettrait l'efficacité de la stérilisation.
La stérilisation proprement dite s'effectue par autoclavage à cent vingt et un degrés Celsius sous une pression de quinze livres par pouce carré pendant au minimum vingt minutes. Les boîtes doivent être placées dans des contenants appropriés, couvercle légèrement entrouvert pour permettre la pénétration de la vapeur. Après stérilisation, elles sont conservées dans leur emballage stérile jusqu'à utilisation, minimisant ainsi les risques de recontamination. Cette méthode garantit l'élimination de toutes les formes végétatives et sporulées de micro-organismes.
Manipulation et observation des cultures : bonnes pratiques au laboratoire
La manipulation des boîtes de Petri contenant des cultures actives requiert des précautions spécifiques pour préserver l'intégrité des échantillons et la sécurité de l'environnement de travail. Le port systématique de gants en nitrile et d'un masque de protection de type II à trois couches constitue la base de l'équipement de protection individuelle. Ces équipements, disponibles pour des prix très accessibles auprès de fournisseurs spécialisés, représentent un investissement minimal au regard de la protection qu'ils offrent.
Toute manipulation de cultures doit être effectuée dans une zone dédiée, idéalement sous une hotte à flux laminaire ou à proximité immédiate d'une flamme stérilisante. Les boîtes ne doivent jamais être ouvertes complètement mais seulement suffisamment pour permettre l'opération nécessaire, réduisant ainsi l'exposition aux contaminants aéroportés. Les observations doivent être conduites rapidement mais méthodiquement, en maintenant les boîtes le plus près possible de la surface de travail pour limiter les mouvements d'air.
L'utilisation d'aiguilles d'injection stériles permet d'effectuer des prélèvements ciblés de mycélium ou de colonies bactériennes sans perturber l'ensemble de la culture. Ces instruments à usage unique, proposés à des prix dérisoires, garantissent l'absence de contamination croisée entre différentes cultures. Après utilisation, toutes les boîtes contenant des cultures doivent être éliminées selon les protocoles de gestion des déchets biologiques, impliquant généralement une inactivation par autoclavage avant mise au rebut.
La consultation régulière des fiches produits et des avis d'utilisateurs permet d'affiner continuellement les pratiques et de bénéficier de l'expérience collective de la communauté scientifique. Cette démarche d'amélioration continue, associée à une sélection rigoureuse du matériel, garantit la qualité et la reproductibilité des expérimentations menées avec ces outils essentiels que sont les boîtes de Petri.
